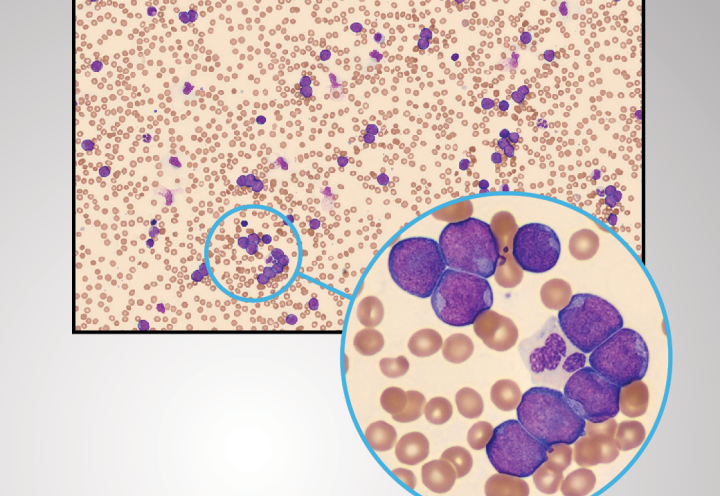

Patient case studies by CellaVision
Four times a year, we publish a Patient Case that everyone can read and share. We illustrate the patient cases with images from CellaVision devices and write them in collaboration with our scientific team.
Monthly Cell Challenges
Every month, we publish a Monthly Cell Challenge on our LinkedIn channel. We share a description of a case, cell images and differentials. Discover our Monthly Cell Challenges or verify your result!
In need of more information?
Would you like to learn more about our product concept, request a demonstration, or get in touch with CellaVision or your local CellaVision distributor?